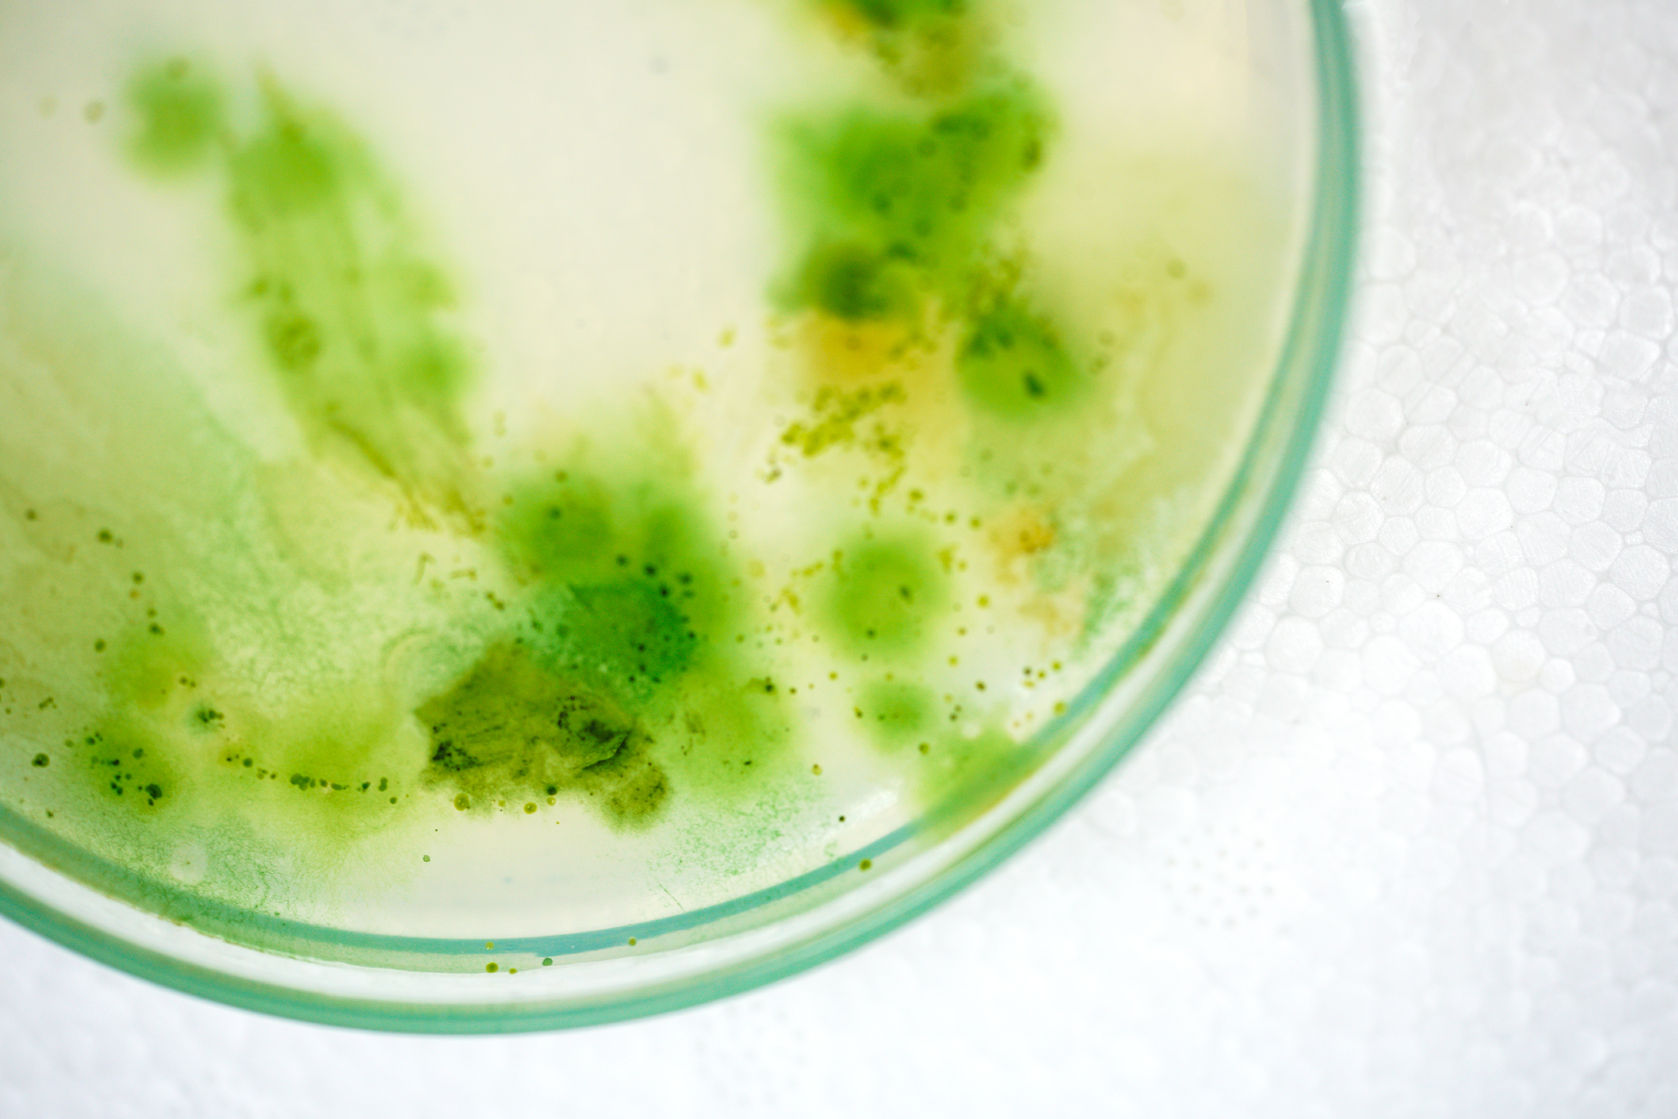
Ako na riasy v jazierku. Dlhá vláknitá riasa alebo zelená voda?

Leto to sú prázdniny, slniečko, voda a kúpanie. Pokiaľ máme na záhrade priestranné jazierko, kde sa môžeme osviežiť alebo aj zaplávať, tak je to v tropických dňoch doslova výhra. Bohužiaľ niekedy sa stane že nám radosť p...
Rady a tipy, Strana 2
Ak je jazierko primárne určené pre chov okrasných rýb, je dosť dôležitý jeho tvar a hĺbka. Pre bezpečné zimovania rýb sa uvádza hĺbka minimálne jeden meter. Čím je jazierko hlbšie, tým lepšie, a to platí aj v lete, kedy ...
Presný objem vášho záhradného jazierka je veľmi dôležitá informácia. Na objeme jazierka totiž závisí funkčnosť danej filtrácie či účinnosť prípravkov proti riasam či baktérií do jazierka. Poznať presný objem vody vo vašo...
Všetci sme už netrpezlivo čakáme jar. Niet sa čomu diviť, keď slnečné lúče a denné teploty cez 10 ° C v nás prebudí aktivitu jarnej prípravy záhrady, vrátane jazierka. Kedy teda sprevádzkovať filtráciu v jazierku? Odpo...
Klimatické výkyvy posledných niekoľkých rokov, suché horúce leto a mierne zimy, začínajú robiť vrásky nejednému chovateľovi rýb v jazierku. Ryby sa aj niekoľkokrát počas zimy prebúdzajú a ukladajú opäť k hibernáciu. Tiet...
Na rok 2019 som si pre Vás prichystali niekoľko noviniek. Prvou novinkou je prírodný prípravok pre zvýšenie obranyschopnosti rýb proti chorobám Probiotic Pond. Je to prípravok osahující rybie probiotické mikroorganizmy, ...
Baktérie sú prirodzenou súčasťou každého ekosystému a nie je tomu inak ani vo vode jazierka. Baktérie by sme si pre naše vysvetlenie mohli zjednodušene rozdeliť na tie: ❌ Zlé: Pôvodcami rôznych chorôb, tvorby toxínov či...
Stráca sa vám voda v jazierku? Možno ide o poškodenú fóliu, ktorou z jazierka uniká voda. Alebo môže ísť aj o odpar vody. Pozrime sa spoločne na tieto dva spôsoby straty vody v záhradnom jazierku. Klesá nám hladina v ja...
K letu patria tropické teploty pri, ktorých vznikajú búrky doplnené prívalovými lejakmi. Posledné roky sú horúce letné dni aj v dobe keď podľa kalendára stále vládne jar. Za vinu sa to dáva klimatickým zmenám. A čo jazie...
Teploty pomaly rastú a horúce letné dni sú za dverami, kúpacie jazierko nám nespočetne krát príde vhod na kúpanie a osvieženie v horúcich letných dňoch. Nie je nič lepšie ako sa vykúpať v čistej vode vlastného záhradného...
Každý, kto má záhradné jazierko riešil alebo rieši problém s riasou. V jazierku sú dva typy rias: vláknitá dlhá riasa (mnohobunková stielka) zelená voda (jednobunková riasa) Niekedy sa ľudia pl...
Všetci sa tešíme, až zima ustane. Všetci nie, ale my určite áno. Jeden z najkrajších pohľadov na jazierko je na jar. Všetko je v rozpuku príroda sa prebúdza, tráva zelená. Často zelená aj voda v jazierku, a to nám celý ...
Každý majiteľ jazierka pozná a používa baktérie. Ale prečo sa používajú a akú majú funkciu? Veľa predajcov či výrobcov argumentuje biorovnováhou v jazierku, ale čo znamená biorovnováha a ako sa tvorí? Baktérie v jazierk...
A najlepšie sa mu spí, keď je mráz po celú zimu a na zamrznutom ľade jazierka sneh prašan, aby jazierko mohlo dýchať. Plyny prestupujú aj cez ľad, ak na ňom nie je roztopený sneh. Zimný "spánok" nastáva aj u našich šupin...
Nesmieme zabudnúť zostrihať rastliny a z jazierka dostať čo najviac organických nečistôt a zvyškov, ktoré sa mohli za celú sezónu nahromadiť. Obzvlášť dôležité je to vtedy, ak chováme ryby, pre ktoré je jazierko aj zimov...
Veľa z vás si povie, čo robím zle? Jazierko aj filtrácie po zime vyčistené, naštartované baktériami a voda krásne čistá. A po necelom mesiaci zrazu sa krištáľovo čistá voda v jazierku mení, znižuje sa transparentnosť a p...
Jarná údržba a naštartovanie jazierka je veľmi dôležité, pretože sa od toho odvíja celá sezóna, preto by sa mala vykonávať dôkladne a tým predchádzať eventuálnym problémom po zvyšok roka. Najprv skontrolujte obvod jazie...